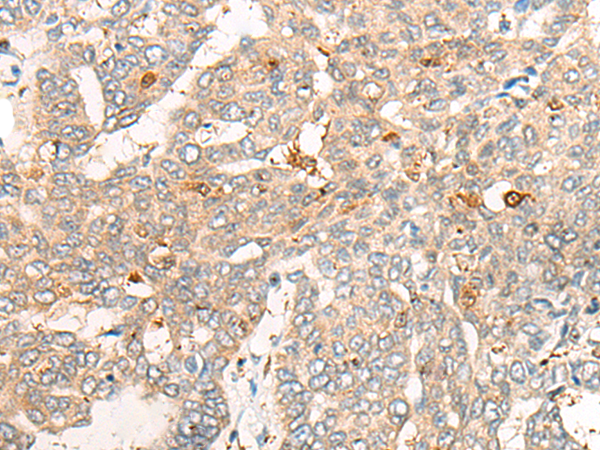

|
Background: |
CNDP2, also known as tissue carnosinase and peptidase A (EC 3.4.13.18), is a nonspecific dipeptidase rather than a selective carnosinase (Teufel et al., 2003 [PubMed 12473676]). |
|
Applications: |
ELISA, IHC |
|
Name of antibody: |
CNDP2 |
|
Immunogen: |
Fusion protein of human CNDP2 |
|
Full name: |
CNDP dipeptidase 2 (metallopeptidase M20 family) |
|
Synonyms: |
CN2; CPGL; PEPA; HsT2298; HEL-S-13 |
|
SwissProt: |
Q96KP4 |
|
ELISA Recommended dilution: |
5000-10000 |
|
IHC positive control: |
Human esophagus cancer and Human colorectal cancer |
|
IHC Recommend dilution: |
25-100 |

購物車
購物車 幫助
幫助
 021-54845833/15800441009
021-54845833/15800441009
